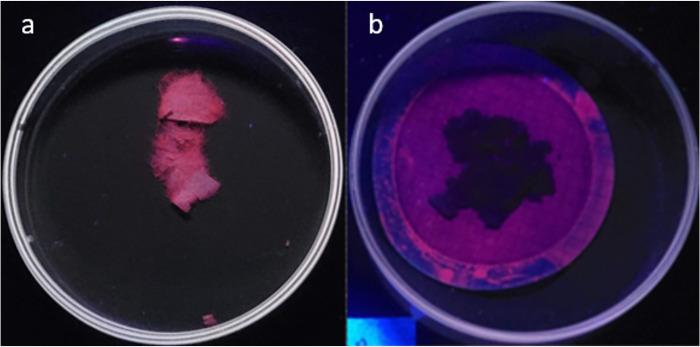
https://cdn.ncbi.nlm.nih.gov/pmc/blobs/fdc5/11651601/15812eb5d611/pone.0314520.g003.jpg

基于微波辅助酸消解开发一种测定沉积物中PET微塑料的新方法。
Development of a new methodology for the determination of PET microplastics in sediment, based on microwave-assisted acid digestion.
作者信息
Perez Marco, Parra Sonnia, Ferrada Cristofher, Bravo Manuel, Perez Pablo A, Quiroz Waldo
机构信息
Instituto de Química, Pontificia Universidad Católica de Valparaíso, Valparaíso, Chile.
Departamento de Ciencias Farmacéuticas, Facultad de Ciencias, Universidad Católica Del Norte, Antofagasta, Chile.
出版信息
PLoS One. 2024 Dec 17;19(12):e0314520. doi: 10.1371/journal.pone.0314520. eCollection 2024.
Analytical methods for the determination of microplastics in sediments typically involve matrix drying, sieving, grinding, and flotation as part of the sample treatment. However, the real need for these steps and analytical validation studies are scarce. This work proposes a method that avoids the drying, sieving, and flotation procedures by using a direct acid attack of HNO₃/HCl (3:1) on wet sediment samples, assisted by microwave digestion. For detection, induced fluorescence using a UV camera, with Nile Red (NR) as the fluorophore and a cell phone camera for image capture were used. The results showed that when the digestion temperature was raised to 120°C, PET recovery decreased due to plastic particle fusion. However, at 60°C, microwave digestion resulted in a 97% recovery of PET particles, eliminating chitin interference and canceling cellulose fluorescence without the need for flotation. This method proved effective for monitoring plastic microparticles in sediments from the Loa River, Chile, revealing that the river is predominantly contaminated with PET microparticles, particularly upstream in the Taira area.
沉积物中微塑料测定的分析方法通常包括基质干燥、筛分、研磨和浮选等样品处理步骤。然而,对这些步骤的实际需求以及分析验证研究却很少。这项工作提出了一种方法,通过在微波消解辅助下,对湿沉积物样品直接进行HNO₃/HCl(3:1)酸攻击,避免了干燥、筛分和浮选程序。在检测方面,使用了以尼罗红(NR)为荧光团的紫外相机诱导荧光,并使用手机相机进行图像采集。结果表明,当消解温度升至120°C时,由于塑料颗粒融合,PET回收率下降。然而,在60°C时,微波消解使PET颗粒的回收率达到97%,消除了几丁质干扰,消除了纤维素荧光,无需浮选。该方法被证明对监测智利洛阿河沉积物中的塑料微粒有效,揭示出该河流主要被PET微粒污染,特别是在泰拉地区的上游。